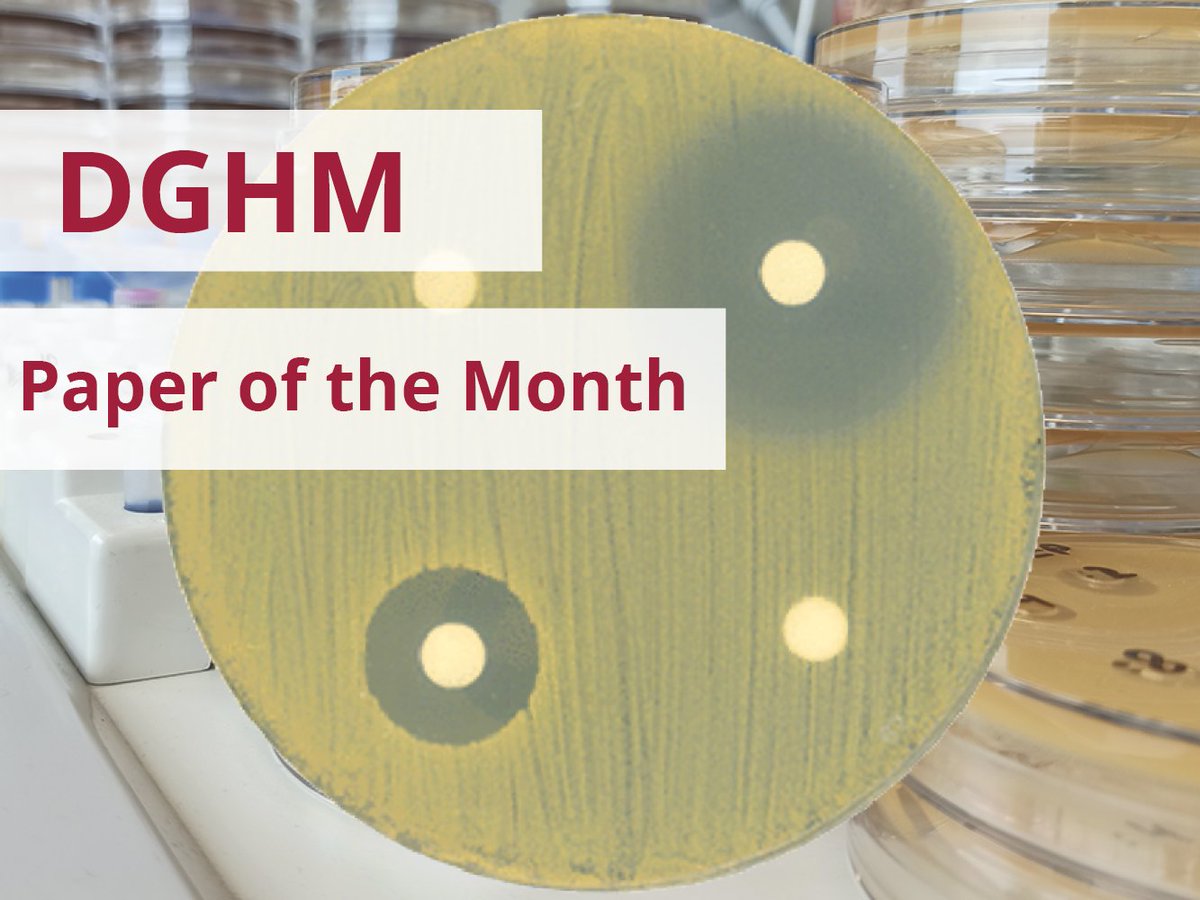
CMFI publication elected 
🎉#DGHM "Paper of the Month" 🎉

“S. aureus Genomes Harbor Only MpsAB-Like Bicarbonate Transporter but Not Carbonic Anhydrase as Dissolved Inorganic Carbon Supply System”

<a href="/JournalSpectrum/">Microbiology Spectrum</a> <a href="/ASMicrobiology/">ASM</a> 

➡️bit.ly/3H03Vq3

Sook-Ha Fan
@sook_ha_fan
Postdoctoral Research Fellow
ID: 1412164026663120901
05-07-2021 21:39:14
10 Tweet
26 Followers
47 Following

Our latest paper is finally out! Controlling Microbes to Fight Infections ANTIBIOTIC CellMAP Staphylococcus aureus Genomes Harbor Only MpsAB-Like Bicarbonate Transporter but Not Carbonic Anhydrase as Dissolved Inorganic Carbon Supply System | Microbiology Spectrum journals.asm.org/doi/10.1128/Sp…



A new publication from my previous colleagues to kickstart 2022! Great job everyone! Controlling Microbes to Fight Infections ANTIBIOTIC CellMAP journals.asm.org/doi/10.1128/mb…

We are thrilled to announce, that the registration for our 3rd International conference CMFI 2023 is now open! We are happy to receive your registration here ➡️cmfi2023.com! Please RT and spread the word! Universität Tübingen Uniklinikum Tübingen @MPI_Bio DFG public | @[email protected]